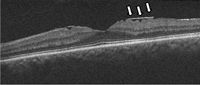

Tomografía de coherencia óptica en la patología macular no traccional: serosa central, agujero macular y membrana epiretiniana
MA. Zapata
Tomografía de coherencia óptica en la coroidorretinopatía serosa central
La tomografía de coherencia óptica (OCT) se ha convertido en una herramienta indispensable para el diagnóstico y el seguimiento de la coroidorretinopatía serosa central (CSC).
Diagnóstico
La sospecha diagnóstica de la CSC es eminentemente clínica, y suele confirmarse mediante angiografía fluoresceínica y OCT (
Figura 1). Recientemente, nuevos estudios con verde de indocianina y el desarrollo de nuevas OCT que permiten un mejor estudio de la coroides han relevado claves que hacen pensar en un origen coroideo de la enfermedad
1-3.

Figura 1. Coroidorretinopatía serosa central aguda en ojo derecho. Se objetiva punto de fuga en la angiografía fluoresceínica y desprendimiento neurosensorial de la retina.
Formas agudas4,5
La tomografía en las formas agudas muestra un desprendimiento neurosensorial. A diferencia de otras enfermedades, como la degeneración macular, en la CSC suele existir una conservación parcial de la retina externa y del epitelio pigmentario, y se aprecia un alongamiento moderado de los segmentos externos de los fotorreceptores, la desaparición de la capa elipsoide, una disminución del grosor de la capa nuclear externa y normalidad en la membrana limitante externa (
Figura 2 y
Figura 3).

Figura 2. Hallazgos en la coroidorretinopatía serosa central aguda. Se aprecia un desprendimiento neurosensorial, con disminución de la capa nuclear externa. La membrana limitante externa aparece conservada. Existe un alargamiento de los fotorreceptores y una alteración de la capa elipsoide (flechas blancas).

Figura 3. A) Varón joven con coroidorretinopatía serosa central aguda. B) Se aprecia un gran desprendimiento de la retina neurosensorial con afectación foveolar. En el corte tomográfico se muestra un desprendimiento localizado del epitelio pigmentario con la doble imagen epitelio pigmentario-membrana de Bruch y material hiporreflectivo entre ellas. C) La angiografía objetiva cómo el desprendimiento del epitelio coincide con el punto de fuga. D) Resolución espontánea del desprendimiento neurosensorial a los 2 meses.
Es frecuente observar pequeños desprendimientos del epitelio pigmentario (
Figura 3B), que suelen corresponder a puntos de fuga en la angiografía. Se especula que son el origen de la enfermedad, aunque no se conoce con exactitud el mecanismo por el que se forman. Estos desprendimientos del epitelio pigmentario de la retina suelen asociar una imagen doble de EPR-membrana de Bruch, con material normalmente hiporreflectivo entre estas capas
6. Estas lesiones pueden ser similares a los pólipos que se objetivan en la vasculopatía polipoidea coroidea, y el diagnóstico diferencial debe realizarse por los otros hallazgos acompañantes, la clínica y las características del paciente, y en última instancia por angiografía fluoresceínica y verde de indocianina.
En determinadas formas de rápida evolución puede encontrarse fibrina asociada. La fibrina se objetiva en el fondo de ojo por el color amarillento, y en ocasiones puede confundirse con depósitos viteliformes. La OCT muestra una hiperreflectividad de la fibrina, que puede contrastar con zonas de desprendimiento neurosensorial seroso dando el aspecto de un nivel.
La coroides aparece engrosada en estos pacientes. Existe un adelgazamiento de la capa interna de la coroides y un gran aumento de los espacios coroideos externos, que se aprecia incluso en ojos sanos contralaterales (
Figura 4).

Figura 4. Coroidorretinopatía serosa central aguda. Se aprecian los signos típicos de las formas agudas: desprendimiento neurosensorial, alargamiento de fotorreceptores y pérdida de la integridad de la capa elipsoide. En este caso se aprecia un aumento en la reflectividad en las capas internas de la coroides (flechas blancas) y un aumento de los espacios coroideos externos (delimitados por flechas amarillas).
Formas crónicas
La OCT en las formas crónicas presenta signos propios. Se objetiva un desprendimiento neurosensorial, con un alargamiento mayor de los fotorreceptores. En ocasiones se pierde la integridad de la membrana limitante interna y el epitelio pigmentario puede presentar un aspecto irregular, con la aparición de pequeños depósitos en forma de joroba. Estas lesiones pueden hacer que se confunda con facilidad la CSC con formas ocultas de neovascularización coroidea. En las formas crónicas puede asociarse atrofia de la retina e incluso edema macular (
Figura 5).

Figura 5. Forma crónica de coroidorretinopatía serosa central. Se aprecia una imagen en reguero en la autofluorescencia. Se objetiva una atrofia de la retina externa, disminución de la capa nuclear externa, desaparición de la membrana limitante externa y capa elipsoide.
La coroidorretinopatía serosa central puede dejar como secuelas una atrofia de la retina que suele ser a costa de la retina externa y alteraciones en el epitelio pigmentario (
Figura 5).
Estudio en face
El estudio
en face permite obtener una idea más clara del desprendimiento de la retina neurosensorial y de las alteraciones en el epitelio pigmentario de la retina (
Figura 6). Se han descrito la presencia de puntos hiperreflectivos en el epitelio pigmentario de la retina y cavitaciones en la coroides
7, aunque hasta la fecha no se conocen las implicaciones que pueden tener tales hallazgos. Con el desarrollo de OCT de muy alta resolución, el estudio en face puede ayudar a la valoración de la red vascular coroidea; por su alta definición puede sustituir a la angiografía y facilitar el diagnóstico diferencial con algunas formas de degeneración macular asociada a la edad
8.

Figura 6. Estudio en face de un paciente con coroidorretinopatía serosa central aguda. Se delimita con facilidad el desprendimiento neurosensorial.

Tabla 1. Resumen de los hallazgos tomográficos en la coroidorretinopatía serosa central, en su forma aguda y crónica, y secuelas que puede dejar en el estudio con OCT.
Seguimiento
Se hace imprescindible el seguimiento de las lesiones por OCT. Las formas agudas suelen presentar una evolución benigna en un 90% de los casos, por lo que es conveniente su control tomográfico. Diferentes autores aconsejan el control mediante agudeza visual y tomografía durante los primeros 3 meses, sin realizar tratamiento mientras se objetive una reducción en el grado de desprendimiento (
Figura 3D).
La tomografía también puede poner de manifiesto lesiones de la enfermedad a largo plazo. De forma crónica es posible observar la persistencia de fluido subretiniano y alteraciones pigmentarias con atrofia de las capas externas de la retina.
Papel de la coroides en la coroidorretinopatía serosa central
La aparición de OCT de dominio espectral y de alta definición ha abierto la puerta para el estudio de la coroides en diferentes enfermedades, entre ellas la CSC.
Se ha objetivado que los pacientes con CSC muestran un engrosamiento de la coroides respecto a los sujetos sanos y también respecto al ojo contralateral al que ha sufrido la lesión.
No se conoce con exactitud el papel de esto en la enfermedad, así como las cavitaciones coroideas que muestran algunos pacientes
7. El tratamiento con terapia fotodinámica no parece modificar el grosor coroideo
9.
Tomografía de coherencia óptica en el agujero macular
Hallazgos tomográficos en el agujero macular
La OCT permite diferenciar con claridad el agujero macular de grosor completo de otras patologías que pueden ser similares en la exploración funduscópica, como los agujeros lamelares y los pseudoagujeros. La exploración con OCT muestra un defecto de todas las capas de la retina.
En formas recientes de agujero macular puede verse conservación de la capa elipsoide y de la membrana limitante interna en los bordes del agujero (
Figura 7). En formas con una mayor cronicidad suele perderse la integridad de la capa elipsoide y de la membrana limitante externa, aparece un levantamiento de los bordes con un edema quístico en los márgenes del agujero y se aprecian alteraciones del epitelio pigmentario (
Figura 8).

Figura 7. Agujero macular de reciente aparición. Se objetiva un defecto completo de todas las capas de la retina. Es posible apreciar con claridad la membrana limitante interna (flechas blancas) y la capa elipsoide (flechas rojas) en los márgenes del agujero.

Figura 8. Agujero macular crónico. Se aprecia un levantamiento de los bordes del agujero, con edema quístico. En los márgenes del agujero no pueden diferenciarse la membrana limitante interna y la capa elipsoide.
Nueva clasificación de la tracción vitreomacular y del agujero macular
La primera clasificación del agujero macular fue hecha por Gass en los años 1980 y era una clasificación muy precisa, fruto de la exploración exhaustiva de los pacientes. Con la aparición de la OCT se hizo una primera revisión, y con la introducción de nuevos tratamientos, como la vitreólisis enzimática, se realizó una nueva clasificación que incluye no sólo los hallazgos, sino que además aporta valor pronóstico desde el punto de vista del tratamiento.
La clasificación actual, propuesta por Duker
et al.
10, es sencilla y fácil de recordar, está basada en la experiencia clínica, se relaciona como hemos dicho con indicaciones terapéuticas y con pronóstico quirúrgico, y es útil para ensayos clínicos (
Tabla 2). Esta clasificación valora los hallazgos aparecidos en al menos un corte de OCT, aunque se recomienda la realización de cubos para una mayor detección de la patología. Describe los hallazgos en un radio de 3 mm de la fóvea.

Tabla 2. Nueva clasificación de las alteraciones en la interfase vitreoretiniana propuesta por Duker et al.10
Tomografía de coherencia óptica en el seguimiento y la resolución del agujero macular
Cierre espontáneo
Es posible observar el cierre espontáneo en un 50% de las tracciones vitreomaculares con agujeros maculares incompletos (grado I en la antigua clasificación por OCT)
11 (
Figura 9), pero sólo se consigue la resolución espontánea en un 2% a un 4% de los agujeros de grosor completo (grados 2-4 de la antigua clasificación)
11,12.

Figura 9. Cierre espontáneo de agujero macular de grosor incompleto y tracción vitreomacular. Se objetiva un agujero que implica las capas externas de la retina, aunque no llega a ser completo en las capas más internas. Se produce un cierre espontáneo a lo largo de 3 meses de seguimiento. El paciente conservaba agudeza visual, pero refería metamorfopsias y leve escotoma central que se desaparecieron tras la resolución del cuadro.
Otro subgrupo en el que puede objetivarse el cierre espontáneo es el de los agujeros maculares traumáticos. Según la serie estudiada
13,14, entre un 10% y un 40% de estas lesiones pueden cursar con cierre en los primeros 3 meses (
Figura 10), aunque en ocasiones este se acompaña de una atrofia de la retina secundaria al traumatismo. Los agujeros maculares traumáticos presentan unas particularidades respecto a los idiopáticos
15: suelen ser más delgados y no asocian signos de cronicidad (como edema quístico), son de base más ancha e irregulares, y en muchos casos persiste la adherencia de la hialoides posterior. Se han propuesto varios patrones por OCT sin que se hayan relacionado con pronóstico visual
16.

Figura 10. Cierre espontáneo de agujero macular traumático. Se aprecia en la retinografía el edema del polo posterior. En la tomografía inicial se objetivan las particularidades de estos agujeros: son más anchos en la base, no suelen asociar signos de cronicidad ni edema quístico y habitualmente son irregulares.
Cierre quirúrgico
El cierre quirúrgico en agujeros maculares completos se sitúa actualmente por encima del 90%, según la serie estudiada. Los factores que pueden afectar el cierre quirúrgico son
7 el tamaño de la lesión (de mejor pronóstico los de tamaño pequeño, menos de 400 µm), los signos de cronicidad y la técnica utilizada. Existen recomendaciones internacionales en cuanto a que la técnica de elección sería la vitrectomía pars plana, con disección de la membrana limitante interna y gas intraocular
17. No queda claro que la colocación en decúbito prono mejore los resultados
18 (
Figura 11).

Figura 11. Cierre quirúrgico de agujero macular de grosor completo. A) Imagen del paciente 2 años antes de desarrollar el agujero macular; se aprecia la existencia de una membrana epiretiniana sin apenas modificación de la anatomía macular. B) Agujero macular completo de pequeño tamaño (prácticamente los bordes se tocan), con levantamiento de los márgenes y edema quístico. C) Imagen 3 meses después de la cirugía mediante vitrectomía y pelado de la membrana limitante interna.
Cierre por vitreólisis enzimática
Recientemente ha salido al mercado la ocriplasmina, el primer fármaco capaz de realizar una vitreólisis enzimática. Está indicada en pacientes con tracciones vitreomaculares sintomáticas y agujeros maculares con tracción vitreomacular asociada
7 (
Figura 12). Los pacientes que parecen beneficiarse más de este fármaco son los jóvenes, fáquicos y sin membrana epiretiniana
19.

Figura 12. Tracción vitreomacular con agujero macular (incompleto). Se realizó tratamiento con vitreólisis enzimática (ocriplasmina).
Tomografía de coherencia óptica en face en el agujero macular
La OCT en face puede aportar nueva información sobre el estado del agujero macular y su cierre quirúrgico. Una de las particularidades observada son las alteraciones en la superficie de la retina en el postoperatorio, más evidentes en los pacientes en quienes se realiza pelado de la membrana limitante interna, pero no se conocen con exactitud las implicaciones que esto pueda conllevar
20 (
Figura 13).

Figura 13. Tomografía en face en paciente intervenido de agujero macular de grosor completo mediante vitrectomía y pelado de la membrana limitante interna. Se aprecian las alteraciones en la superficie en forma de “pocillos”, de predominio en zona temporal.
Tomografía de coherencia óptica en la membrana epiretiniana
La OCT puede ser de gran ayuda en el diagnóstico y el control de las membranas epiretinianas.
En la OCT se aprecia una línea hiperreflectiva independiente que queda por encima de la membrana limitante interna. Dependiendo del tipo y del estadio de la membrana pueden encontrarse otras características: conservación de la depresión foveolar, engrosamiento de la retina interna, pliegues en la retina interna, adherencias focales de la membrana con separación parcial de la retina, imagen de pseudoagujero macular, cambios quísticos en la retina central y existencia de agujeros lamelares (
Figura 14 y
Figura 15). Existen clasificaciones anatómicas y sintomáticas de las membranas epiretinianas, aunque hasta la fecha no hay consenso en cuanto a su utilización.
Figura 14. Membrana epiretiniana. Se aprecian adherencias focales de la membrana, con pliegues en la retina interna (flechas blancas), sin modificación de la depresión foveolar.

Figura 15. Membrana epiretiniana con importante engrosamiento de la anatomía macular.
En el seguimiento posquirúrgico, la OCT ayuda a valorar la recuperación anatómica de la fóvea y la normalización del engrosamiento y de los pliegues en la retina interna. También puede ser útil para la monitorización del cierre de los agujeros lamelares (
Figura 16).

Figura 16. A) Existencia de membrana epiretiniana con engrosamiento y pliegues de la retina interna. Se aprecia un agujero lamelar. B) Un mes después de la intervención quirúrgica se objetiva la ausencia de la membrana, con una resolución parcial del agujero lamelar.
La tomografía en face puede ser útil para poner de manifiesto los pliegues que ocasiona la membrana en la retina interna (
Figura 17). También puede resultar interesante el estudio
en face posquirúrgico para correlacionar la normalización de los pliegues y las metamorfopsias.

Figura 17. Imágenes en face de membranas epiretinianas. Se objetivan con facilidad los epicentros de las membranas y los pliegues radiales que generan en la retina interna.
Bibliografía
-
Guyer DR, Yannuzzi LA, Slakter JS, Sorenson JA, Ho A, Orlock D. Digital indocyanine green videoangiography of central serous chorioretinopathy. Arch Ophthalmol. 1994;112:1057-62.
-
Spaide RF, Hall L, Haas A, et al. Indocyanine green video-angiography of older patients with central serous chorioretinopathy. Retina. 1996;16:203-13.
-
Imamura Y, Fujiwara T, Margolis R, Spaide RF. Enhanced depth imaging optical coherence tomography of the choroid in central serous chorioretinopathy. Retina. 2009;29:1469-73.
-
Roisman L, Lavinsky D, Magalhaes F, Aggio FB, Moraes N, Cardillo JA, et al. Fundus autofluorescence and spectral domain OCT in central serous chorioretinopathy. J Ophthalmol. 2011;2011:706-849.
-
Fujimoto H, Gomi F, Wakabayashi T, Sawa M, Tsujikawa M, Tano Y. Morphologic changes in acute central serous chorioretinopathy evaluated by fourier-domain optical coherence tomography. Ophthalmology. 2008;115(9):1494-500.
-
Yang L, Jonas JB, Wei W. Optical coherence tomography-assisted enhanced depth imaging of central serous chorioretinopathy. Invest Ophthalmol Vis Sci. 2013;54:4659-65.
-
Lehmann M, Wolff B, Vasseur V, Martinet V, Manasseh N, Sahel JA, et al. Retinal and choroidal changes observed with ‘En face’ enhanced-depth imaging OCT in central serous chorioretinopathy. Br J Ophthalmol. 2013;97(9):1181-6.
-
Ferrara D, Mohler KJ, Waheed N, Adhi M, Liu JJ, Grulkowski I, et al. En face enhanced-depth swept-source optical coherence tomography features of chronic central serous chorioretinopathy. Ophthalmology. 2014;121(3):719-26.
-
Razavi S, Souied EH, Cavallero E, Weber M, Querques G. Assessment of choroidal topographic changes by swept source optical coherence tomography after photodynamic therapy for central serous chorioretinopathy. Am J Ophthalmol. 2014;157(4):852-60.
-
Duker JS, Kaiser PK, Binder S, de Smet MD, Gaudric A, Reichel E, et al. The International Vitreomacular Traction Study Group classification of vitreomacular adhesion, traction, and macular hole. Ophthalmology. 2013;120(12):2611-9.
-
La Cour M, Friis J. Macular holes: classification, epidemiology, natural history and treatment. Acta Ophthalmol Scand. 2002;80:579-87.
-
Freeman WR, Azen SP, Kim JW, et al. Vitrectomy for the treatment of full-thickness stage 3 or 4 macular holes. Results of a multicentered randomized clinical trial. The Vitrectomy for Treatment of Macular Hole Study Group. Arch Ophthalmol. 1997;115:11-21.
-
Yamashita T, Uemara A, Uchino E, Doi N, Ohba N. Spontaneous closure of traumatic macular hole. Am J Ophthalmol. 2002;133(2):230-5.
-
Li XW, Lu N, Zhang L, Wang WW, Wang Y, Yan W, et al. Follow-up study of traumatic macular hole. Zhonghua Yan Ke Za Zhi. 2008;44(9):786-9.
-
Huang J, Liu X, Wu Z, Sadda S. Comparison of full-thickness traumatic macular holes and idiopathic macular holes by optical coherence tomography. Graefes Arch Clin Exp Ophthalmol. 2010;248(8):1071-5.
-
Huang J, Liu X, Wu Z, Lin X, Li M, Dustin L, et al. Classification of full-thickness traumatic macular holes by optical coherence tomography. Retina. 2009;29(3):340-8.
-
Spiteri Cornish K, Lois N, Scott NW, Burr J, Cook J, Boachie C, et al. Vitrectomy with internal limiting membrane peeling versus no peeling for idiopathic full-thickness macular hole. Ophthalmology. 2014;121(3):649-55.
-
Solebo AL, Lange CA, Bunce C, Bainbridge JW. Face-down positioning or posturing after macular hole surgery. Cochrane Database Syst Rev. 2011;(12):CD008228.
-
Stalmans P, Benz MS, Gandorfer A, Kampik A, Girach A, Pakola S, et al. Enzymatic vitreolysis with ocriplasmin for vitreomacular traction and macular holes. N Engl J Med. 2012;367(7):606-15.
-
Alkabes M, Salinas C, Vitale L, Burés-Jelstrup A, Nucci P, Mateo C. En face optical coherence tomography of inner retinal defects after internal limiting membrane peeling for idiopathic macular hole. Invest Ophthalmol Vis Sci. 2011;52(11):8349-55.